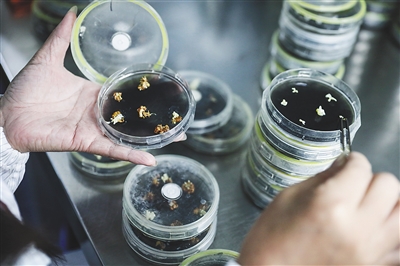

文\海南日报记者 邱江华
橡胶树是海南种植面积最大的树,行走在琼州大地,人们经常能看到成片的胶林。但你是否留心过,橡胶树是怎么长大的?
“橡胶种子埋在地里,开始抽芽,长成树苗,再慢慢长成枝叶繁茂的大树……”你的脑海里也许会浮现这样的场景,这是原始而传统的橡胶种植方法。在中国热带农业科学院(以下简称中国热科院),橡胶种植有了新的打开方式——组培橡胶苗。
奇
橡胶苗长在试管里
上万支试管紧密有序地摆在实验室货架上,里面是一株株颜色青翠、娇小可爱的橡胶苗。它们有的刚从胚芽里吐出一点嫩叶,有的已长成有模有样的小树苗。橡胶苗长在试管里,这是海南日报记者近日在中国热科院天然橡胶新型种植材料创新基地看到的新鲜事。
“这是橡胶树组培苗,又叫自根幼态无性系或体胚苗,是橡胶树第三代种植材料。它们相当于橡胶苗里的‘克隆军’。”中国热科院橡胶研究所良种良苗研究室主任黄天带介绍说,这些橡胶苗在试管里长到10厘米左右,就可以移栽到温室大棚内,再长到60厘米,就可以移到地里定植。
为何要在试管里培育橡胶苗?黄天带告诉记者,以前种植橡胶树使用的树苗主要有实生苗和芽接苗。橡胶实生苗是指直接用橡胶种子播种萌芽,这样长大的植株具备生长快、经济寿命长等优点,但产量不高。目前这种种植材料已基本被淘汰。橡胶芽接苗则是指将优良母树的芽片接到种子苗上,借助芽片繁殖优良胶树,芽接苗能保持母树干胶产量较高的特点,但其生长慢、经济寿命短。橡胶树组培苗兼具实生苗和芽接苗的优点,推广种植价值高。
探
移栽橡胶花药体细胞植株
为了找到一种生长快、适应性强、产量高的橡胶树种植材料,从20世纪六七十年代开始,全球范围内的橡胶育种专家们不约而同开始了探索。
“那时候,植物组织培养技术迅猛发展,橡胶组培研究随之开启。”黄天带解释说,植物的组织培养可以理解为离体培养,是近几十年发展起来的一项无性繁殖新技术。具体路径为:从植物体分离出符合需要的组织、器官或细胞等,通过无菌操作,将之接种在含有各种营养物质及植物激素的培养基上,进行培养以获得再生的完整植株。
相关资料显示,1977年前后,中国热科院的橡胶育种专家成功获得了橡胶花药体细胞的完整植株,并移栽成活。这是世界上第一批移栽成活的橡胶花药体细胞植株。
如今,记者在中国热科院天然橡胶新型种植材料创新基地实验室看到的“试管橡胶苗”,是中国热科院橡胶研究所科研人员用优良母本的花药,应用该所独立研发的组织培养技术培育出的种苗。黄天带表示,橡胶树组培苗具有完整继承母株特性、生长速度快、抗性优良等优点,相较于橡胶树芽接苗,能增产10%到30%。
拼
突破橡胶树组织培养技术瓶颈
橡胶树组培苗技术成功研发后的几十年里,全球从事橡胶育种的专家们在这一领域不断有新的研究成果,但始终无法解决大规模生产的难题,因此该技术未能走向实际应用。
为此,中国热科院橡胶所于2006年专门组建了橡胶树组培与转基因育种团队,由中国热科院橡胶研究所所长、天然橡胶产业体系首席科学家黄华孙和研究员华玉伟领衔,专门攻关橡胶树组培苗工厂化生产技术。
“如何将一株橡胶苗变成一万株?如何将实验室里细心呵护的橡胶苗,变成室外能抵抗风雨的橡胶树?我们一直在找这两个问题的答案。”回忆起那些年的攻关经历,黄天带感触很深。她是华玉伟的妻子,比丈夫早几年进入中国热科院橡胶研究所工作。“组建团队后,我们一心扑在了科研上。”
橡胶树有花期。为了选择最理想的橡胶花用于体胚培养,每次临近花期,黄天带和华玉伟白天做实验,下班后就立马钻进胶园里观察橡胶花。“把科研做出了赶农忙的感觉!”黄天带笑道,就连在饭桌上,她和丈夫也经常谈论科研中遇到的难题。
“到2008年的时候,成活率依旧很低。实验室里1000多株橡胶树组培苗,移栽到室外仅存活了10棵,成活率在1%左右。”黄天带叹了一口气说,前几年科研没做出成果,大家心里都堵堵的。
后来,一次偶然的机会,华玉伟受到法国相关科学研究的启发,开始采用另一种实验方法——他将橡胶花药诱导的体胚切成小块,转入愈伤诱导培养基,再进一步诱导体胚发生。没想到,这样操作居然获得了大量正常的体细胞胚!
华玉伟和黄天带为此欣喜若狂,他们在此基础上抓紧完善了橡胶出苗、移栽等程序,建立了橡胶树次生体胚再生体系,突破了制约橡胶树组织培养近40年的技术瓶颈。这一成果获得了2012年海南省科技进步奖二等奖。
“过去一个工人一年能生产200株橡胶苗,我们就认为他非常能干了。我们的新技术应用后,到了2019年,一个工人一年能生产两万株橡胶苗,产量足足提升了100倍!”黄天带自豪地说。
赞
我国率先实现橡胶树组培苗规模化生产
“你看,这就是我们认为最优质的苗,主根粗壮,须根也很发达,根尖白白的正用力地往下扎……”黄天带时不时就会去实验室里转两圈,看一看橡胶树组培苗的生长情况。这些茁壮成长的橡胶苗,是中国热科院几代橡胶育种专家辛勤耕耘、默默奉献的结晶,大家看着它们,就像看着自己的孩子一般,眼中充满了柔情与怜爱。
黄天带告诉记者,中国热科院天然橡胶新型种植材料创新基地今年7月才建成投入使用,具备年产橡胶树组培苗100万株的能力,在世界上首次实现了橡胶树组培苗的规模化生产,其生产技术国际领先,吸引了法国、印度、缅甸等国家的科研人员前来“取经”。
“相比过去,现在的科研条件好很多。”黄天带记得,她刚刚参与橡胶树组培苗工厂化生产技术研究时,实验环境简陋,达不到无菌的条件。“每年四五月份梅雨季节,空气潮湿,实验材料容易受污长霉,一旦长霉就意味着前功尽弃,耽误了我们不少时间。”
为了克服困难,中国热科院橡胶研究所的科研人员专门发明了一种透明的培养皿,这种培养皿有密封圈和透气装置,既能产生密封的效果,又能透气,大大降低了实验材料发霉的概率。
如今,在新建成的天然橡胶新型种植材料创新基地,从进门到抵达实验室要经过好几个消杀环节,有专门的实验服,也配备了专门的大容量高压灭菌锅用于实验材料灭菌。科研人员在里面有条不紊地开展各项工作。目前,他们生产的橡胶树组培苗已经种到了海南、云南、广东三大植胶区,推广面积达2万多亩,明显地提高了当地橡胶树的产量,促进了胶农增收致富。
本版图片均由海南日报记者 张茂 摄